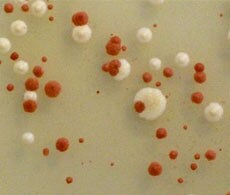
yeast-showcase yeast-showcase

Search
Search
A key component of gene functional analysis and drug target discovery is an understanding of how proteins interact within the cell. The ProQuest™ Two-Hybrid System with Gateway® Technology is a tested, robust, in vivo yeast-based system for identifying protein-protein interactions. It provides specially engineered components for bait and prey expression, and enables the rapid movement of sequences between the ProQuest™ system and other expression and analysis tools using simple recombinant cloning.
pDEST™ 32 bait vector
pDEST™22 prey vector
pEXP-AD502 prey vector
pEXP32/Krev1
pEXP22/RalGDS-wt
pEXP22/RalGDS-m1
pEXP22/RalGDS-m2
仅供科研使用,不可用于诊断目的。